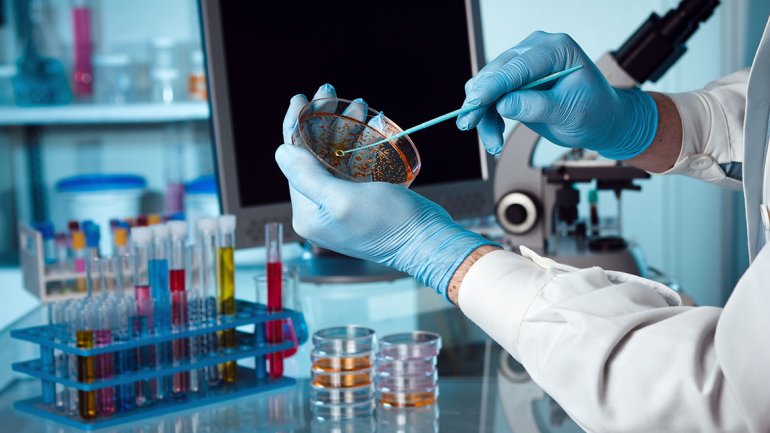

Iraníes forman cadenas humanas frente a centrales eléctricas y puentes ante las amenazas de TrumpNuevas autoridades del Banco del Chaco: Livio Gutiérrez asumió la presidenciaSin casos de dengue en el Chaco: Salud fortalece la prevención en todo el territorioUna chaqueña quedó varada en medio de la guerra en Irak y pide ayuda para salir con su bebéLa mitad de los habitantes del país vive con menos de $15 mil por día